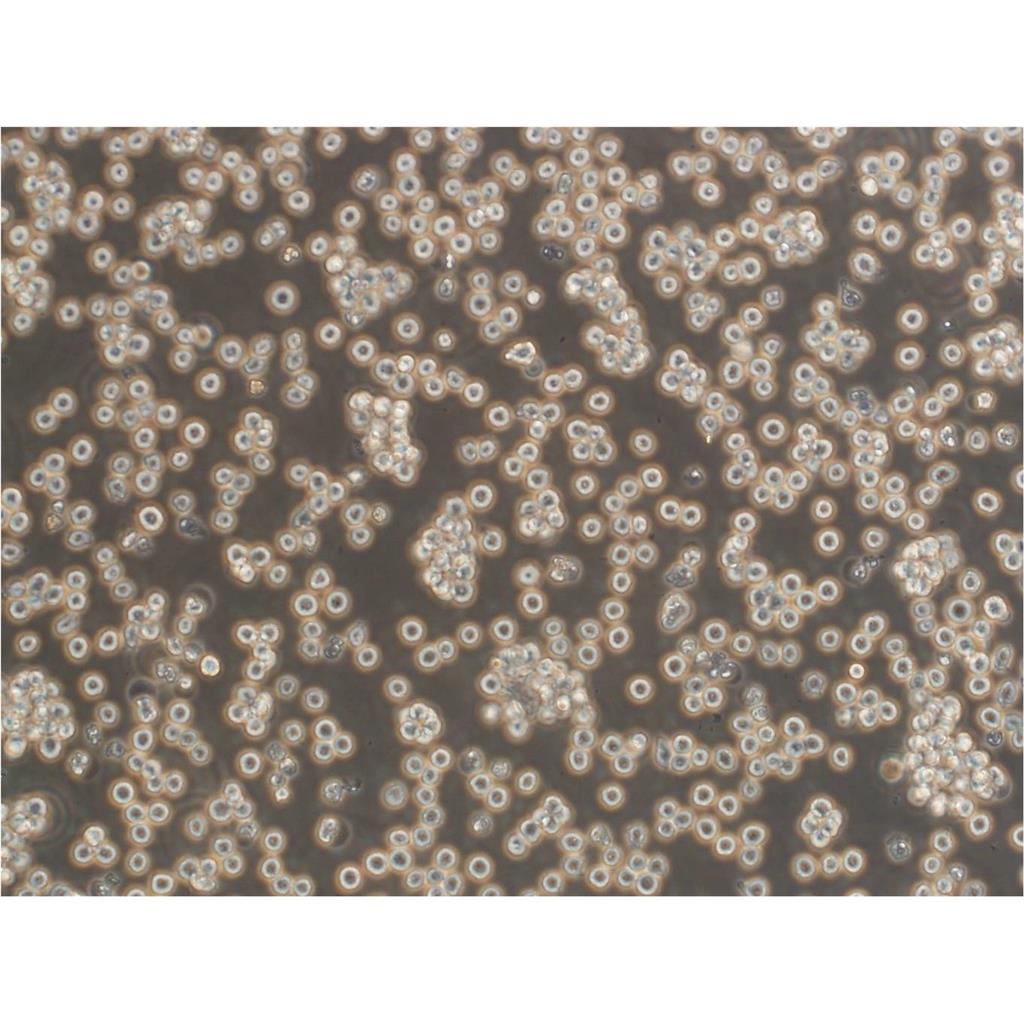
Mono-Mac-6 Cells人急性单核细胞白血病细胞传代率高|STR图谱

"Mono-Mac-6 Cells人急性单核细胞白血病细胞传代率高|STR图谱
【形态特性】
Mono-Mac-6 Cells人急性单核细胞白血病细胞传代率高|STR图谱淋巴母细胞样
【Mono-Mac-6 Cells人急性单核细胞白血病细胞传代率高|STR图谱英文别名】
MONO-MAC-6; Mono-mac-6; MONO-MAC 6; Mono Mac 6; Mono Mac6; MonoMac 6; MonoMac6; MONOMAC6; MM6
【生长特性】
Mono-Mac-6 Cells人急性单核细胞白血病细胞传代率高|STR图谱悬浮生长
【污染检测】
支原体、细菌、酵母和真菌检测为阴性。
【细胞接收流程】
收到细胞后,应首先观察细胞状态,然后进行75%酒精消毒处理。将细胞置于37℃培养箱中放置2-4小时以稳定Mono-Mac-6 Cells人急性单核细胞白血病细胞传代率高|STR图谱状态。当细胞密度达到80%-90%时,即可进行首次传代培养。
定期检测细胞培养液的无菌状态是必要的。可以通过以下方法进行检测:污染的培养液通常会出现浑浊、变色或沉淀物增多的现象。定期在显微镜下观察细胞状态,如发现异常漂浮物或细胞形态改变,可能提示污染。取少量培养液接种于细菌或真菌培养基中,37°C培养24-48小时,观察是否有微生物生长。
消化时间的把控同样关键。理想状态是细胞刚好从培养皿脱落但仍保持完整形态。实际操作中,显微镜下观察细胞边缘回缩、间隙增大时即应终止消化。常见误区是等待所有细胞完全脱落,这往往意味着部分细胞已过度消化。温度对消化效率的影响也不容忽视。37℃可显著提高胰酶活性,但同时也加速了消化进程,增加操作难度。对于娇嫩细胞,建议在室温(22-25℃)下进行消化,虽然时间稍长但更易控制。离心步骤中的细节同样重要。离心力过大(如超过300g)或时间过长(超过5分钟)会导致细胞机械损伤,而不足的离心力则使细胞沉淀不充分,影响后续接种均匀性。
【消化传代】
使用0.25%胰酶-EDTA溶液,37°C孵育1-2分钟,轻拍培养瓶促进细胞脱落。(悬浮细胞可省略这步操作)
【传代比例】
1:2-1:4(Mono-Mac-6 Cells人急性单核细胞白血病细胞传代率高|STR图谱首次传代建议1:2)
【背景信息】
Mono-Mac-6 Cells人急性单核细胞白血病细胞传代率高|STR图谱详见相关文献介绍
【细胞状态】
传代和消化过程中,应密切关注细胞状态,避免过度消化或机械损伤导致细胞活性下降。
【空泡现象】
在密集培养时,细胞中可见巨大的空泡,这是细胞的正常特性,无需担心。
【血清比例】
使用10%-20%的血清浓度有助于优化Mono-Mac-6 Cells人急性单核细胞白血病细胞传代率高|STR图谱实验条件,提高实验的重复性和稳定性。这一浓度范围经过多年实验和实践的验证,被认为是较为适宜的选择。
【操作规范】
在细胞培养和处理过程中,需严格遵守无菌操作规范,以避免细胞污染和交叉污染。
【消化条件】
室温下用胰酶消化1-3分钟。
【培养条件】
37°C、5%CO₂、饱和湿度环境,使用含10%-20%FBS的基础培养基。
【来源说明】
Mono-Mac-6 Cells人急性单核细胞白血病细胞传代率高|STR图谱主要来源ATCC、ECACC、DSMZ、RCB等细胞库
【污染防控】
严格无菌操作,定期检测支原体污染,必要时使用双抗预防细菌污染。
烘箱(干燥箱)的干热灭菌功能对玻璃器皿至关重要。鼓风式设计确保160℃高温下热量均匀分布,但操作中存在三个技术要点:一是必须同步启动鼓风与加热功能,避免局部过热;二是100℃以下才能开启箱门,防止玻璃器皿因骤冷破裂;三是需使用耐高温牛皮纸包裹器械,普通棉质材料在高温下碳化产生的微粒可能影响细胞贴壁。有新研发的真空烘箱将灭菌时间缩短30%,同时降低能源消耗。
细胞培养瓶破裂或渗漏是实验室最紧急的情况之一。当发现容器破损时,应立即执行三级处理流程:首先将破损培养瓶放入生物安全柜,用消毒剂浸泡的纱布覆盖裂口;随后将培养物转移至备用培养瓶,转移过程需严格保证无菌操作;最后对工作台面进行彻底消毒。值得注意的是,聚乙烯材质的培养瓶在反复冻融后更易产生微裂纹,建议使用前进行透光检查。对于珍贵细胞系,可预先分装冻存备份,并建立定期镜检制度,每周至少两次检查培养容器完整性。
【培养观察】
定期观察Mono-Mac-6 Cells人急性单核细胞白血病细胞传代率高|STR图谱生长状态,注意培养基的pH值变化和细胞密度,及时换液和传代。
【细胞复苏】
复苏细胞时,应快速将冻存管从液氮中取出并置于37℃水浴中解冻,然后转移到含新鲜培养基的无菌管中并吹打混匀。整个复苏过程应尽可能在5-10分钟内完成,以确保细胞的高存活率。
【细胞传代】
传代时,应使用适量的胰蛋白酶溶液进行消化,并在显微镜下观察细胞消化情况。消化下来的细胞容易成团,需要吹打吹散。传代后,应确保细胞均匀分布在培养瓶或培养皿中。
【生物安全等级】
1级。
【换液周期】
Mono-Mac-6 Cells人急性单核细胞白血病细胞传代率高|STR图谱每周2-3次
【产品包装】
复苏发货:Mono-Mac-6 Cells人急性单核细胞白血病细胞传代率高|STR图谱T25培养瓶(一瓶)或冻存发货:1ml冻存管(两支)
【物种来源】
Mono-Mac-6 Cells人急性单核细胞白血病细胞传代率高|STR图谱来源于人源、鼠源等其它物种来源
【细胞冻存】
待细胞生长状态良好时,可进行细胞冻存。一般使用冻存液进行冻存,并置于液氮中储存。
实验人员需佩戴防爆面罩及双层无菌手套,尤其当发现冻存管液氮渗入时(管壁出现冰晶凝结为典型标志)。建议使用专门设计的液氮罐提取器,避免徒手接触-196℃的冻存管导致低温灼伤。解冻前准备37℃恒温水浴锅,水位需完全浸没冻存管液面线以上,并预热至温度稳定(±0.5℃波动范围)。
标准复苏流程包括:快速解冻:将冻存管从液氮中取出后立即置于37℃水浴,持续摇动直至仅剩少量冰晶(通常需1-2分钟),梯度稀释:将细胞悬液缓慢加入预热的完全培养基(含10%血清),逐步降低DMSO浓度离心清洗:1000rpm离心5分钟去除冻存保护剂,重悬接种:按适当密度接种于预处理好的培养器皿。
SHG-44细胞传代性好;背景说明:SHG-44细胞株源自一例2-3级前沿淋巴结星细胞瘤。染色体组型显示89.2%的超三倍体。在Wistar大鼠和裸鼠中接种都能成功。细胞含有神经系统特有的S-100蛋白和星细胞特有的GFA蛋白;传代方法:消化3-5分钟。1:2。3天内可长满。;生长特性:贴壁生长;形态特性:成纤维细胞样;相关产品有:H4细胞传代性好、A253细胞传代性好、SF295细胞
NCI-H128细胞传代性好;背景说明:小细胞肺癌;胸腔积液转移;男性;传代方法:1:2-1:3传代;每周换液2-3次。;生长特性:贴壁;形态特性:详见产品说明书;相关产品有:UO.31细胞传代性好、YTMLC-90细胞传代性好、GM03573A细胞
Abcam RAW 264.7 Cd68 KO Cells(提供STR鉴定图谱)
HR-1细胞传代性好;背景说明:详见相关文献介绍;传代方法:每2-3天换液;生长特性:悬浮生长 ;形态特性:淋巴母细胞样;相关产品有:HEK293F细胞传代性好、Walker-256-TC细胞传代性好、SNU638细胞
DK-MG细胞传代性好;背景说明:胶质母细胞瘤;女性;传代方法:1:2-1:3传代;每周换液2-3次。;生长特性:贴壁;形态特性:详见产品说明书;相关产品有:CAL-12T细胞传代性好、NRCC细胞传代性好、OCI-LY-18细胞
CMT-93细胞传代性好;背景说明:结肠癌;C57BL/ICRF;传代方法:1:2-1:3传代;每周换液2-3次。;生长特性:贴壁;形态特性:详见产品说明书;相关产品有:Bac1 2F5细胞传代性好、D341MD细胞传代性好、H1105细胞
TER268 Cells(提供STR鉴定图谱)
SKOV3-eGFP Cells人卵巢癌细胞传代性好|有STR图谱
AMO-1 Cells人骨髓浆细胞瘤细胞传代性好|有STR图谱
HFSF Cells人胚胎眼巩膜成纤维细胞传代性好|有STR图谱
MLO-Y4 Cells小鼠骨样细胞传代性好|有STR图谱
OVCAR-5 Cells人转移性胃肠癌细胞传代性好|有STR图谱
HUVEC-C Cells人脐静脉内皮细胞传代性好|有STR图谱
HSC-5 [Human skin squamous cell carcinoma]细胞传代性好;背景说明:皮肤鳞癌;男性;传代方法:1:2-1:3传代;每周换液2-3次。;生长特性:贴壁;形态特性:详见产品说明书;相关产品有:Y3M细胞传代性好、HPAF2细胞传代性好、MLM细胞
Porcine Kidney-13细胞传代性好;背景说明:详见相关文献介绍;传代方法:1:2—1:4传代,每周换液2—3次;生长特性:贴壁生长;形态特性:上皮细胞样;相关产品有:H-1048细胞传代性好、P3HRI细胞传代性好、HPAF II细胞
UPCISCC154细胞传代性好;背景说明:舌鳞癌;男性;HPV6转化;传代方法:1:2-1:3传代;每周换液2-3次。;生长特性:贴壁;形态特性:详见产品说明书;相关产品有:FTC133细胞传代性好、SK-N-BE(1)n细胞传代性好、138 MG细胞
HIT细胞传代性好;背景说明:胰岛β细胞;SV40转化;传代方法:1:2-1:3传代;每周换液2-3次。;生长特性:贴壁;形态特性:详见产品说明书;相关产品有:SUM-52细胞传代性好、PLA801C细胞传代性好、MEL-526细胞
HCC1588细胞传代性好;背景说明:肺鳞癌;女性;传代方法:1:2-1:3传代;每周换液2-3次。;生长特性:贴壁;形态特性:详见产品说明书;相关产品有:H-211细胞传代性好、MDA-kb2细胞传代性好、H-3255细胞
SK-N-DZ Cells人神经母细胞瘤细胞传代性好|有STR图谱
786-O Cells人肾透明细胞腺癌细胞传代性好|有STR图谱
GP2-293 Cells人胚肾上皮包装细胞传代性好|有STR图谱
NCI-H187 Cells人小细胞肺癌细胞传代性好|有STR图谱
SK-MES1细胞传代性好;背景说明:源于一位65岁患有肺鳞状细胞癌的白人男性,自转移性胸腔积液分离而来。;传代方法:1:2传代;生长特性:贴壁生长;形态特性:上皮样;相关产品有:G519细胞传代性好、MCF7-CTRL细胞传代性好、MB468细胞
HCEC-B4G12细胞传代性好;背景说明:角膜;内皮细胞;SV40转化;女性;传代方法:1:2-1:3传代;每周换液2-3次。;生长特性:贴壁;形态特性:详见产品说明书;相关产品有:AX-Mel细胞传代性好、MNNG细胞传代性好、H-1975细胞
HLE-SRA-01/04细胞传代性好;背景说明:晶状体;上皮细胞;SV40转化;男性;传代方法:1:2-1:3传代;每周换液2-3次。;生长特性:贴壁;形态特性:详见产品说明书;相关产品有:Panc2.03细胞传代性好、CEMC7细胞传代性好、NTera 2细胞
SUP-M2细胞传代性好;背景说明:详见相关文献介绍;传代方法:1:2-1:3传代;每周换液2-3次。;生长特性:贴壁或悬浮,详见产品说明书部分;形态特性:详见产品说明书;相关产品有:SW1271细胞传代性好、D283MED细胞传代性好、Baby Hamster Kidney-21细胞
MC-116细胞传代性好;背景说明:详见相关文献介绍;传代方法:每周换液2-3次。;生长特性:悬浮生长 ;形态特性:淋巴母细胞样;相关产品有:SBC3细胞传代性好、NPA87-1细胞传代性好、H-510细胞
MB468细胞传代性好;背景说明:该细胞是1977年由CailleauR等从一位患有转移性乳腺癌的51岁黑人女性的胸腔积液中分离得到的。虽然供体组织的G6PD等位基因杂合,但此细胞株始终表现为G6PDA表型。P53基因273位密码子存在G→A突变,从而导致Arg→His替代。每个细胞上存在1×106个EGF受体。;传代方法:1:2-1:4传代;2-3天换液1次;生长特性:贴壁生长;形态特性:上皮样;相关产品有:Pt-K2细胞传代性好、BT325细胞传代性好、HEK-293A细胞
BRL-3A Cells大鼠肝细胞传代性好|有STR图谱
RPMI-8226 Cells人多发性骨髓瘤外周血B淋巴细胞传代性好|有STR图谱
LoVo Cells人结肠癌细胞传代性好|有STR图谱
E14 Cells小鼠胚胎干细胞传代性好|有STR图谱
CA-OV-3细胞传代性好;背景说明:该细胞1976年建系,源自一位54岁白人女性的卵巢腺癌组织。;传代方法:1:3传代,2—3天换液一次;生长特性:贴壁生长;形态特性:上皮样;相关产品有:HIT T15细胞传代性好、VK2 (E6/E7)细胞传代性好、L6565细胞
MM134细胞传代性好;背景说明:该细胞1973年由R. Cailleau建系,源自74岁乳腺导管癌女性患者的胸腔积液,细胞生长缓慢,松散贴壁,生长过程中会脱落到培养基,不会汇合,过表达FGF受体;传代方法:1:2—1:4传代,每周换液2—3次;生长特性:松散贴壁生长;形态特性:上皮细胞样;相关产品有:H526细胞传代性好、SKOV-433细胞传代性好、KFB细胞
H1703细胞传代性好;背景说明:该细胞1987年建系,源自一位54岁患有非小细胞肺癌的白人男性,该患者为吸烟者。;传代方法:1:3—1:6传代,每周换液2—3次;生长特性:贴壁生长;形态特性:上皮细胞样;相关产品有:DAKIKI Clone 1细胞传代性好、MDA1386细胞传代性好、CACO2细胞
HAP1 ADRA1A (-) 2 Cells(提供STR鉴定图谱)
HAP1 SHARPIN (-) 1 Cells(提供STR鉴定图谱)
H-64细胞传代性好;背景说明:详见相关文献介绍;传代方法:1:2-1:3传代;每周换液2-3次。;生长特性:贴壁或悬浮,详见产品说明书部分;形态特性:详见产品说明书;相关产品有:IOSE-80细胞传代性好、RDES细胞传代性好、HPASMC细胞
U-138 MG Cells人脑星形胶质母细胞瘤细胞传代性好|有STR图谱
NTERA-2 Cells人恶性多发性畸胎瘤细胞传代性好|有STR图谱
IGROV-1 Cells人卵巢癌细胞传代性好|有STR图谱
CFPAC-1-Luc Cells人胰腺导管癌细胞传代性好|有STR图谱
COLO 205-Luc Cells人结肠癌细胞传代性好|有STR图谱
NCI-H292 Cells人肺癌细胞传代性好|有STR图谱
HCC-LM3 Cells人高转移性肝癌细胞传代性好|有STR图谱
Hs940.T细胞传代性好;背景说明:详见相关文献介绍;传代方法:1:2-1:3传代,2-3天换液1次。;生长特性:贴壁生长;形态特性:成纤维细胞;相关产品有:293 HEK细胞传代性好、UMNSAH-DF 1细胞传代性好、IGROV细胞
HCT GEO细胞传代性好;背景说明:结肠癌;传代方法:1:2-1:3传代;每周换液2-3次。;生长特性:贴壁;形态特性:详见产品说明书;相关产品有:ISHI细胞传代性好、Rainbow Trout Embryo细胞传代性好、T_T_细胞
BT.549细胞传代性好;背景说明:该细胞1978年由W.G.Coutinho和E.Y.Lasfargues建系,源自一位72岁患有乳腺导管癌的白人女性,来源组织包括乳头及浸润导管。该细胞形态包括上皮样细胞及多核巨细胞,可分泌一种粘性物质。;传代方法:1:2传代;生长特性:贴壁生长;形态特性:上皮样;相关产品有:H1755细胞传代性好、KU19-19细胞传代性好、DV90细胞
aTC1-6细胞传代性好;背景说明:胰岛素瘤;a细胞;C57BL/6xDBA/2;传代方法:1:2-1:3传代;每周换液2-3次。;生长特性:贴壁;形态特性:详见产品说明书;相关产品有:WM115mel细胞传代性好、P31FUJ细胞传代性好、RCC-4细胞
Colo699细胞传代性好;背景说明:详见相关文献介绍;传代方法:1:2-1:3传代;每周换液2-3次。;生长特性:贴壁或悬浮,详见产品说明书部分;形态特性:详见产品说明书;相关产品有:H-2330细胞传代性好、H-661细胞传代性好、HCT116/L细胞
NK 10a细胞传代性好;背景说明:1967年,该细胞系KleinE和KleinG建系,源于一名16岁患有Burkitt's淋巴瘤的黑人男性,beta-2-微球蛋白阴性,表达EBNA,VCA,sIg。该细胞携带EB病毒,是一个典型的B淋巴母细胞系,可用于白血病发病机制的研究。;传代方法:1:2传代;生长特性:悬浮生长;形态特性:淋巴母细胞样;相关产品有:NCIH1734细胞传代性好、alpha TC1.6细胞传代性好、MPP-89细胞
SK-N-MC Cells人神经上皮瘤细胞传代性好|有STR图谱
SUM149PT Cells人乳腺癌细胞传代性好|有STR图谱
MDA-MB-231-Luc Cells人乳腺癌细胞传代性好|有STR图谱
HFSF-PI 3 Cells人胚胎眼巩膜成纤维细胞传代性好|有STR图谱
HGC-27 Cells人胃癌细胞传代性好|有STR图谱
HT-29-Luc Cells人结肠癌细胞传代性好|有STR图谱
HMEC-1 Cells人微血管内皮细胞传代性好|有STR图谱
Monomac-1细胞传代性好;背景说明:急性单核细胞白血病;男性;传代方法:1:2-1:3传代;每周换液2-3次。;生长特性:悬浮;形态特性:详见产品说明书;相关产品有:H2228细胞传代性好、Panc 10.05细胞传代性好、SUM190细胞
HyCyte LoVo-Luc Cells(提供STR鉴定图谱)
LCL-IDDM-PI269 Cells(提供STR鉴定图谱)
N2a[TRb1]-Dnmt3a-Cat Domain KO Clone 7 Cells(提供STR鉴定图谱)
TE-1 Cells人食管癌细胞传代性好|有STR图谱
CHO-DXB11 CTLA4 Ig-24 Cells仓鼠卵巢细胞传代性好|有STR图谱
COLO-684细胞传代性好;背景说明:详见相关文献介绍;传代方法:1:2传代;生长特性:悬浮生长;形态特性:详见产品说明书;相关产品有:DMS 273细胞传代性好、NCI-SNU-668细胞传代性好、Hs852细胞
Fetal Human Lens-124细胞传代性好;背景说明:晶状体上皮;自发永生;传代方法:1:2-1:3传代;每周换液2-3次。;生长特性:贴壁;形态特性:详见产品说明书;相关产品有:bEnd.3[BEND3]细胞传代性好、A375-S2细胞传代性好、A-431细胞
ACC-3细胞传代性好;背景说明:Acc-3细胞源自一位49岁男性的腺样囊性癌。能表达角蛋白。;传代方法:消化3-5分钟。1:2。3天内可长满。;生长特性:贴壁生长;形态特性:上皮样;相关产品有:4T1-LUC细胞传代性好、HRA 19细胞传代性好、SUM-149细胞
MC116细胞传代性好;背景说明:详见相关文献介绍;传代方法:每周换液2-3次。;生长特性:悬浮生长 ;形态特性:淋巴母细胞样;相关产品有:Hs839.T细胞传代性好、SCaBER细胞传代性好、IHHA-1细胞
MC116细胞传代性好;背景说明:详见相关文献介绍;传代方法:每周换液2-3次。;生长特性:悬浮生长 ;形态特性:淋巴母细胞样;相关产品有:Hs839.T细胞传代性好、SCaBER细胞传代性好、IHHA-1细胞
NB4 Cells人急性早幼粒细胞白血病细胞传代性好|有STR图谱
SW1088 Cells人脑星形胶质瘤细胞传代性好|有STR图谱
KYSE-410 Cells人食管鳞癌细胞传代性好|有STR图谱
LS513 Cells人结直肠癌细胞传代性好|有STR图谱
OVCAR-5-CisR Cells(提供STR鉴定图谱)
RT4/31 Cells(提供STR鉴定图谱)
Ubigene HCT 116 YWHAE KO Cells(提供STR鉴定图谱)
WBE Cells(提供STR鉴定图谱)
HER1-hiPSC6 Cells(提供STR鉴定图谱)
HPAF II细胞传代性好;背景说明:详见相关文献介绍;传代方法:1:2传代;生长特性:贴壁生长;形态特性:详见产品说明书;相关产品有:MD Anderson-Metastatic Breast-134-VI细胞传代性好、Caki-1细胞传代性好、NUGC2细胞
H22-Luc Cells小鼠肝癌细胞传代性好|有STR图谱
SHZ-88 Cells大鼠乳腺癌细胞传代性好|有STR图谱
CAL-12T Cells人肺癌细胞传代性好|有STR图谱
SNU-368 Cells人肝癌细胞传代性好|有STR图谱
"